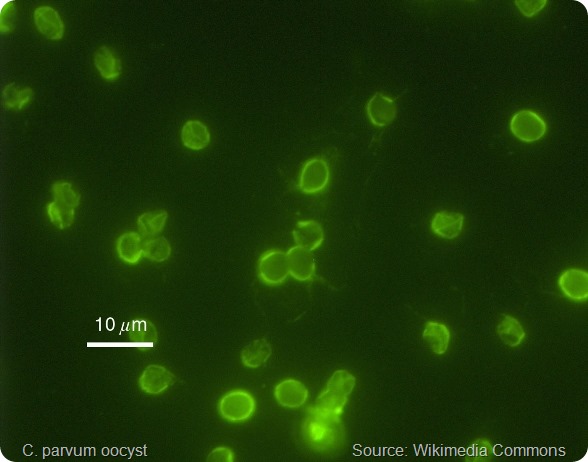
C. parvum

The parasite may be passed from animals to humans or vice versa, which is referred to as zoonotic spread or it may be transmitted between humans which is termed anthroponotic spread.
The prevalence of C. parvum is on the rise in industrialized countries and has been shown to be present in almost 90% of raw water sampled across the United States and Canada.
Another way the disease can be contracted indirectly is through environmental contamination when sewage or wastewater fails to be adequately contained and overflows after heavy rainfall.
Surface water and the crops produced by agriculture can also become contaminated with fecal waste from various types of livestock which also contributes to the amount of zoonotic transmission.
Why does C. parvum spread rapidly and what makes it so resistant to water decontamination techniques such as chlorination?
The parasite’s gametes fuse to form an oocyst, a structure with a wall containing 4 sporozoites (immature forms of the parasite) that is highly robust to the external environment.
Oocysts are also instantly infectious once shed in the feces, where they may be present in numbers of up to 1 million in each stool. They can also still be excreted for up to 2 months after a bout of diarrhea has passed.
In addition, their infectivity potential is high, with just 1 to 10 oocysts capable of causing illness in healthy individuals.
Furthermore, oocysts are still infectious after 6 months if their environment stays moist enough. They are also resilient to decontamination agents such as chlorine and can survive in recreational establishments such as water parks or pools for well over a week.
The parasite’s very long incubation period, which can last as long as 30 days, means spread of the protozoa can go on unnoticed for days before health authorities eventually recognize that there has been an outbreak.
Finally, individuals with lowered immunity such as children in areas where the disease is widespread and those with compromised immunity are at the greatest risk.
How does C. parvum cause cryptosporidiosis and how dangerous is this condition?
After the oocyst is ingested, its sporozoites escape from the cyst (a process called excystation) and target the enterocytes lining the small intestine.
They then multiply both sexually and asexually to produce macrogametocytes and microgametocytes. Microgametes fertilize macrogametocytes to produce a zygote which undergoes sporulation and gives rise to oocysts with thin walls that further infect the host as well as more robust oocysts with thick walls that leave the host on excretion.
Once outside the body of the host and in the external environment, the parasite has the potential to cause enteric infection.
In humans, cryptosporidiosis causes sickness and a bout of severe diarrhea that can have serious, life-threatening consequences if it infects individuals who are elderly, very young or who lack protective immunity, such as those with HIV infection.
How does C. parvum escape the body’s immune system?
Proteases play a role in vital aspects of the parasite’s life cycle such as the degradation of protein, host tissue invasion and avoidance of the immune system.
Cysteine protease has been suggested to play a part in the oocyst excystation stage.
In addition, protease inhibitors have been associated with the prevention of infection, suggesting that proteases may be integral to the infective capabilities of C.parvum.
Why are there currently no reliable treatments for cryptosporidiosis?
The only drug approved by the FDA for the treatment of cryptosporidiosis is nitazoxanide. This agent has been demonstrated to both increase cure rates and reduce symptom duration and severity in infected individuals with healthy immune systems.
In a randomized trial of 3-day nitazoxanide treatment, 80% of individuals receiving the drug were free of diarrhea within 7 days of starting treatment compared with just 41% of those who received placebo.
However, nitazoxanide is not an effective treatment for individuals with HIV, even in the case of extended treatment or increased doses. Similarly, an agent called paromomycin, which usually offers some protection against C. parvum is also ineffective among those with HIV or AIDS.
For people with HIV, management of cryptosporidiosis is focused on boosting the immune system with combination antiretroviral therapy. Protease inhibitor therapies which also offer some protection against parasitic activity may be beneficial in these individuals.
Please can you outline your recent research that identified a protease inhibitor that can block the parasite’s ability to evade the immune system?
We used four mammalian cell lines to investigate the Clan CA cysteine protease inhibitor, N-methyl piperazine-Phe-homoPhe-vinylsulfone phenyl (K11777) and found that the drug has a dose-dependent inhibitory effect on the growth of C. parvum.
At a concentration of 60 µM, K11777 eradicated C.parvum in all four of the cell lines, compared with a 1 to 2 log decrease when the dose was 20 µM and no reduction at all when the dose was only 10 µM. For reference, the use of 700 µM paromomycin only resulted in a 1-2 log reduction in C.parvum numbers in the four cell lines.
In addition, studies of knock-out mice prone to C.parvum showed that K11777 treatment over ten days prevented death in mice infected with the parasite whereas untreated infected mice died within 8 to 11 days.
What impact do you think this discovery will have and do you think it will now be possible to develop an effective treatment for cryptosporidiosis?
The cysteine protease inhibitor does show promise as a potential new drug in the treatment of cryptosporidiosis.
Where can readers find more information?
About Dr. Momar Ndao
 Dr Momar Ndao, a native of Kayemor, Senegal received his DVM from the University Cheikh Anta Diop, Dakar, Senegal. He pursued a Master of Sciences (MSc) and PhD in Parasitology at the Institute of Tropical Medicine, Antwerp, Belgium and completed his post-graduate research in microbiology at McGill University. He is the recipient of numerous awards from Senegal, Switzerland, Belgium and Canada. Dr Ndao is a member of the Infection and Immunity axis of the Research Institute of the McGill University Health Centre (MUHC) is funded by various national funding agencies such as the FRSQ, CIHR and the CFI. Dr Ndao has supervised numerous trainees and students and serves on review committees of various agencies, scientific journals and governments.
Dr Momar Ndao, a native of Kayemor, Senegal received his DVM from the University Cheikh Anta Diop, Dakar, Senegal. He pursued a Master of Sciences (MSc) and PhD in Parasitology at the Institute of Tropical Medicine, Antwerp, Belgium and completed his post-graduate research in microbiology at McGill University. He is the recipient of numerous awards from Senegal, Switzerland, Belgium and Canada. Dr Ndao is a member of the Infection and Immunity axis of the Research Institute of the McGill University Health Centre (MUHC) is funded by various national funding agencies such as the FRSQ, CIHR and the CFI. Dr Ndao has supervised numerous trainees and students and serves on review committees of various agencies, scientific journals and governments.
He is Assistant Professor to the Faculty of Medicine at McGill University, associate member McGill Institute of Parasitology, Department of Microbiology & Immunology and Department of Experimental Medicine. Since 2000 he serves as the Laboratory Director of the National Reference Centre for Parasitology (NRCP) at the Research Institute MUHC. The NRCP is an external reference laboratory for Health Canada whose aim is to evaluate and develop assays, provide reference diagnostic tests, epidemiological/surveillance studies of human parasitoses and parasite-related teaching and research.
Increased awareness of parasitic infections has led to newly recognized parasites, emerging pathogens, and bioterrorism considerations; the fields of diagnostic medical parasitology, treatment and vaccines are undergoing dramatic change. As such, Dr Ndao is actively involved in 1) bringing cutting edge science to diagnose infectious diseases; 2) study of host-parasite interactions; 3) screening drugs to be used as therapies for infectious diseases; 4) developing vaccines to prevent parasitic diseases and 5) applying proteomic technology to discover biomarkers for infectious diseases.